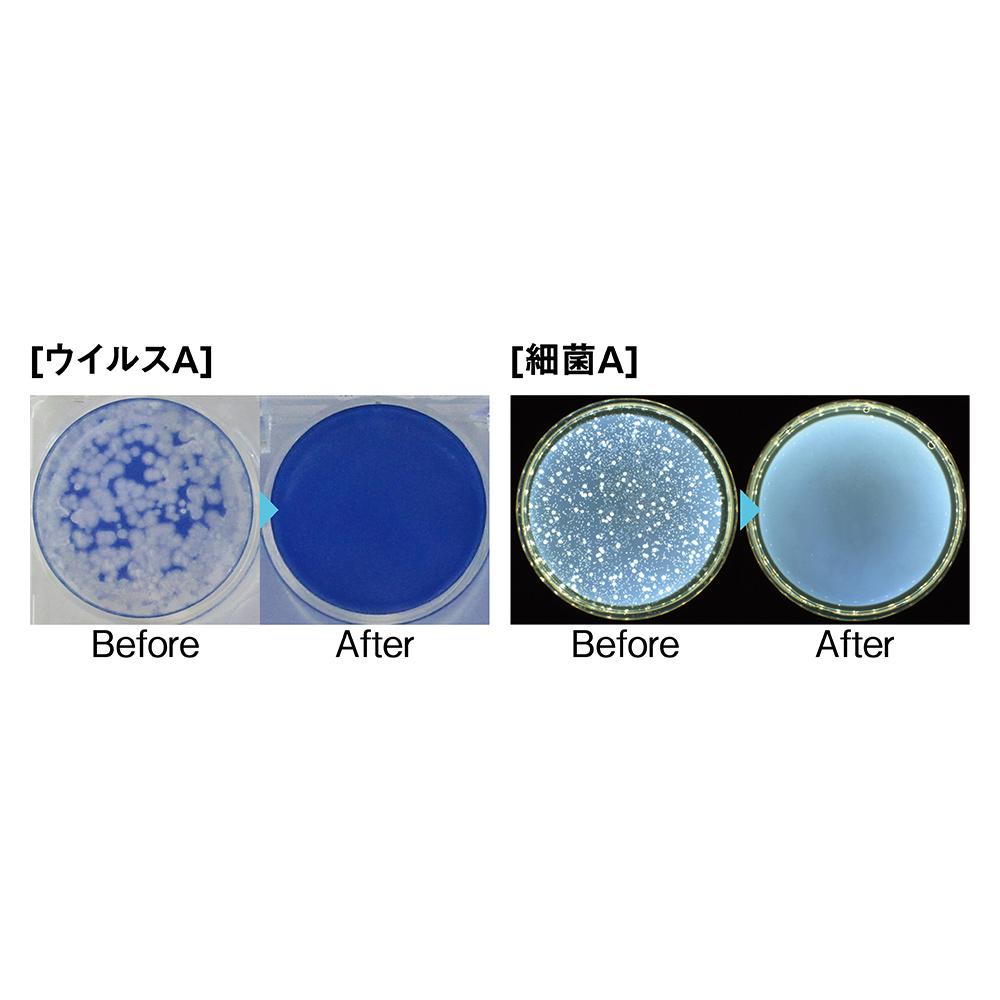

1/11
時点_ポイント最大11倍
≪90×220cm以内≫ アキレス抗ウイルス・抗菌テーブルマット(オーダーカット) テーブルクロス ランチョンマット 送料無料 582119
色
-
色:ヘンケイ
-
色:シカク
販売価格
36,900
円 (税込)
送料込み
- 出荷目安:
- [在庫とお届け予定時期の確認]ボタンから確認下さい
たまるdポイント(通常) 335
+キャンペーンポイント(期間・用途限定) 最大10倍
※たまるdポイントはポイント支払を除く商品代金(税抜)の1%です。
※表示倍率は各キャンペーンの適用条件を全て満たした場合の最大倍率です。
各キャンペーンの適用状況によっては、ポイントの進呈数・付与倍率が最大倍率より少なくなる場合がございます。
dカードでお支払ならポイント3倍
各キャンペーンの適用状況によっては、ポイントの進呈数・付与倍率が最大倍率より少なくなる場合がございます。
- 商品情報
- レビュー
【販売店・発送】株式会社dinos
【申込番号】582119
【商品基本コード】1120705452
ご注文ガイド
仕様・サイズ
[すべてのサイズに共通]
■厚さ約1.5mm
■素材:塩化ビニール(表面抗ウイルス加工、裏面非移行加工)
■耐熱温度:50度
■カッターマット(2枚)、マーカーペン、滑り止めテープ付き
■日本製
■商品送料は商品価格に含まれます。
■商品は素材の特性上、使用環境によっては多少の伸び縮みがありますので大きめの寸法でお届け致します。ご了承ください。
■オーダーカットについて
・サイズ内(※商品名に記載)であれば、円形、六角形、雲形など、ご指定の形状にてサイズカットを承ります。
・各サイズとも寸法内で1枚のカットとなります。(カットは1cm単位でご指定ください。)
・ご注文後、約1週間で採寸キットをお届けいたします。採寸キット(型紙など)に必要事項をご記入の上、ご返送いただきますと、約2週間でオーダー商品をお届けいたします。
・オーダー品のため、お申し込み後のキャンセル・返品はお受けできませんのでご了承ください。
・採寸キットの返送先は商品のオーダーカットを行うメーカーとなります。
・採寸キットをお送りしてから一定期間ご返送が無い場合や、お送りいただいた採寸表についてご確認したい内容がある場合には、メーカーよりお客様にお電話をさせていただく場合がございますので、あらかじめご了承ください。
・素材の特性上、汚れを長時間放置すると色素が沈着する恐れがありますので、汚れた場合はすぐにふき取るようにしてください。
・使用環境によっては多少の伸び縮みがありますので、大きめの寸法でお届けいたします。あらかじめご了承ください。
・採寸キットを紛失された場合、キットを再送する際の費用はお客様のご負担となりますので、あらかじめご了承ください。
・お支払いは商品お届け時となります。
■厚さ約1.5mm
■素材:塩化ビニール(表面抗ウイルス加工、裏面非移行加工)
■耐熱温度:50度
■カッターマット(2枚)、マーカーペン、滑り止めテープ付き
■日本製
■商品送料は商品価格に含まれます。
■商品は素材の特性上、使用環境によっては多少の伸び縮みがありますので大きめの寸法でお届け致します。ご了承ください。
■オーダーカットについて
・サイズ内(※商品名に記載)であれば、円形、六角形、雲形など、ご指定の形状にてサイズカットを承ります。
・各サイズとも寸法内で1枚のカットとなります。(カットは1cm単位でご指定ください。)
・ご注文後、約1週間で採寸キットをお届けいたします。採寸キット(型紙など)に必要事項をご記入の上、ご返送いただきますと、約2週間でオーダー商品をお届けいたします。
・オーダー品のため、お申し込み後のキャンセル・返品はお受けできませんのでご了承ください。
・採寸キットの返送先は商品のオーダーカットを行うメーカーとなります。
・採寸キットをお送りしてから一定期間ご返送が無い場合や、お送りいただいた採寸表についてご確認したい内容がある場合には、メーカーよりお客様にお電話をさせていただく場合がございますので、あらかじめご了承ください。
・素材の特性上、汚れを長時間放置すると色素が沈着する恐れがありますので、汚れた場合はすぐにふき取るようにしてください。
・使用環境によっては多少の伸び縮みがありますので、大きめの寸法でお届けいたします。あらかじめご了承ください。
・採寸キットを紛失された場合、キットを再送する際の費用はお客様のご負担となりますので、あらかじめご了承ください。
・お支払いは商品お届け時となります。
商品の説明
国際基準に準じた「抗ウイルス SIAAマーク」で更にグレードアップ!
食事や家族の団らんの場であるテーブルだけは衛生に気を付けたい!
そんな思いを大好評の「アキレス 透明テーブルマット」が叶えます。
24時間で99.9%の細菌・ウイルスを低減。家中の卓上に欲しい商品です!(※1)
~オーダーカットでご自宅専用のテーブルマットを~
人気の透明テーブルマットシリーズ、より多くのお客様に使っていただきたく、オーダーカットタイプをご用意いたしました。■オススメポイント1【高い抗菌・抗ウイルス効果】
付着したウイルス・菌を24時間で99.9%以上低減することができます。食事や家族団らんの場であるダイニングテーブルには特におススメです。
■オススメポイント2【テーブルマットとしての高いクオリティ】
・テーブルを傷めにくい、研究を重ねた素材を使用・特殊加工で気泡ができにくく、テーブルの見た目を損ねません。
・特殊両面コーティング塩化ビニールを使用しているので、写真をはさんでも転写の心配はありません。
・厚さはこだわりの1.5mm。クッション性は食器の保護に、ペンの跡が残りづらいのでテレワークや学習机としても。
■オススメポイント3【豊富なサイズ展開】
各家庭、また、おうちのなかのテーブルによって、サイズは様々。ぴったりのサイズを選んでいただくために、たくさんのサイズをご用意致しました。
市販のカッターでカンタンにカットできるので、特殊な形状のテーブルにも対応できます。
◎サイズ内(※商品名に記載)であれば、円形、六角形、雲形など、ご指定の形状にてサイズカットを承ります。
◎各サイズとも寸法内で1枚カットとなります。(カットは1cm単位でご指定ください。)
◎ご注文後、約1週間で採寸キットをお届けいたします。採寸キット(型紙など)に必要事項をご記入の上、ご返送いただきますと、約2週間でオーダー商品をお届けいたします。
◎オーダー品のため、お申し込み後のキャンセル・返品はお受けできませんのでご了承ください。
(※1)本商品は病気の治療や予防を目的とするものでは御座いません。
また、抗菌・抗ウイルス性能は全ての菌・ウイルスに対して効果があるものではありません。
抗菌・抗ウイルス性能は試験機関における結果であり、実際の使用状況により異なる場合が御座います。
本製品は商品表面に付着したウイルスに対して発現するものであり、感染予防を保証するものではありません。
商品画像の説明

サイズや用途に合わせたオーダーカットが可能です。
食器棚のクッションシートに。べたつきにくので、ガラス食器などを置いても出し入れしやすく、耳障りな音の解消にも。
円形テーブルの傷も防ぎます。指定の形状にカットが可能です。
テレビボードのクッションカバーとして。重い液晶テレビなどを置くと傷がつきそう。そんなときにもボードの表面を保護。
キッチンカウンターやサイドボードなど、長さのある天板に適した最長300cmのロングサイズが仲間入り。
お子様が使う机にも
様々なウイルスと細菌に効果を発揮するため、口に入れるものを置く場所には特におすすめです。

市販のカッターでお好きなサイズにカットできます。
カウンターテーブルの汚れ防止にもおすすめです。
写真などをはさんでも転写の心配がありません。
しっかりとした厚みで上質感があり、クリアな透明感。表面はサラサラと気持ちの良い感触で、直接手が触れる食卓にもピッタリです。







